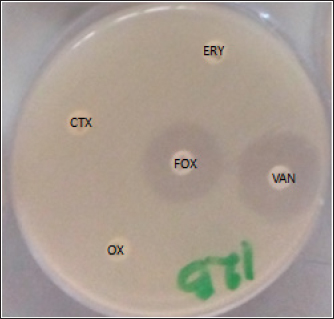

| Research Article | ||
Open Vet. J.. 2024; 14(12): 3327-3335 Open Veterinary Journal, (2024), Vol. 14(12): 3327-3335 Research Article Prevalence and molecular detection of mecA and lukD genes from livestock-associated methicillin-resistant Staphylococcus aureus isolated in raw chicken meats sold in Abakaliki, NigeriaEmmanuel Nnabuike Ugbo1, Agatha Ifunanya Ugbo2, Mustofa Helmi Effendi3, Wiwiek Tyasningsih4*, Bernard Nnabuife Agumah1, Anthonia Chinyere Nwachi1, Aswin Rafif Khairullah5, Ikechukwu Benjamin Moses1, Ricadonna Raissa6 and Sheila Marty Yanestria71Department of Applied Microbiology, Faculty of Science, Ebonyi State University, Abakaliki, Nigeria 2Department of Microbiology and Parasitology, David Umahi Federal University of Health Sciences Uburu, Abakaliki, Nigeria 3Division of Veterinary Public Health, Faculty of Veterinary Medicine, Universitas Airlangga, Surabaya, Indonesia 4Division of Veterinary Microbiology, Faculty of Veterinary Medicine, Universitas Airlangga, Surabaya, Indonesia 5Research Center for Veterinary Science, National Research and Innovation Agency (BRIN), Bogor, Indonesia 6Department of Pharmacology, Faculty of Veterinary Medicine, Universitas Brawijaya, Malang, Indonesia 7Faculty of Veterinary Medicine, Universitas Wijaya Kusuma Surabaya, Surabaya, Indonesia *Corresponding Author: Wiwiek Tyasningsih. Division of Veterinary Microbiology, Faculty of Veterinary Medicine, Universitas Airlangga, Surabaya, Indonesia. Email: wiwiek-t [at] fkh.unair.ac.id Submitted: 24/08/2024 Accepted: 11/11/2024 Published: 31/12/2024 © 2024 Open Veterinary Journal
AbstractBackground: Due to its deadly toxins and ability to produce enzymes, the commensal bacterium Staphylococcus aureus is found in animals, birds, and people. It may also be linked to certain medical disorders. Aim: This study was aimed at the prevalence and molecular detection of mecA and lukD genes from livestock-associated methicilin-resistant S. aureus (LA-MRSA) in raw chicken meats sold in Abakaliki. Methods: The butchers in the slaughterhouses provided 150 fresh raw chicken meat samples, which were then cultured and purified using mannitol salt agar. The LA-MRSA was determined using oxacillin and cefoxitin by a disk diffusion method. A polymerase chain reaction was used to investigate the presence of mecA and lukD genes in the isolates that were resistant to cefoxitin and oxacillin. Results: Exactly, 61 (40.7%) out of the 150 samples analyzed were positive for S. aureus, and 39 (52.0%) and 22 (29.3%) were isolated from broiler and layer chicken meats, respectively. Out of the 61 (40.7%) samples colonized by S. aureus, 7 (11.5%) were identified to be LA-MRSA positive using the phenotypic method. Thus, 5 (12.8%) and 2 (9.1%) were recovered as LA-MRSA positive from broiler and layer chicken meats, respectively. All the LA-MRSA was reported to present three major multidrug resistance index patterns. The overall prevalence of mecA and lukD genes was reported as 2 (28.6%) and 3 (42.9%), respectively. Conclusion: This study confirmed the presence of mecA and lukD in LA-MRSA isolated from chicken in Abakaliki, Nigeria, and is a serious public health threat. Keywords: Chicken meats, mecA, LA-MRSA, lukD, public health. IntroductionThe potential for antibiotic-resistant bacteria in animals to spread to humans as foodborne pathogens is a major cause for concern (Effendi et al., 2018). Methicillin-resistant S. aureus (MRSA) is one of the main developing pathogenic strains causing significant issues in veterinary and human medicine, according to a growing number of reports. However, MRSA is drastically increasing among livestock, humans, and their environments (Wu et al., 2019; Tyasningsih et al., 2019). MRSA can spread through direct contact between humans and animals as well as through the use of contaminated surfaces, food, water, and air (Suleyman et al., 2018; Touimi et al., 2020). MRSA has been linked to unsanitary conditions that occur when food is processed, such as when raw chicken meat is contaminated with bacterial toxins. In addition, poor cooking, inappropriate meat storage, incorrect food preparation using contaminated water, and careless handling by food handlers, including butchers and merchants of raw chicken meat, are additional sources of MRSA contamination in food (Abd El-Ghany, 2021). During the process of butchering birds or preparing meat, chicken flesh may become contaminated with MRSA (Abolghait et al., 2020). The high incidence of MRSA in poultry meat, which is regarded as a major health risk for consumers, is strongly correlated with the rise of MRSA in human zoonotic illnesses (Benrabia et al., 2020). Because of the potential for zoonotic transmission from contaminated retail meat to people or through the food chain, MRSA strains have previously attracted a lot of attention (Wu et al., 2019). A particular kind of bacterium known as livestock-associated methicillin-resistant S. aureus (LA-MRSA) has become resistant to several antibiotics. It has been identified in various countries of the world. LA-MRSA has been recognized as a serious pathogen that presents a zoonotic risk to people, particularly those in intimate contact with the disease (Kinross et al., 2017). LA-MRSA has always been associated with animals and animal products and is linked to transmission from animals to humans. LA-MRSA has been reported worldwide from farm animals such as poultry birds and pigs (Fox et al., 2016). Serious worries regarding potential food contamination have been raised by the discovery that LA-MRSA is present in food-producing animals. Research from Africa, Europe, Asia, and North America has demonstrated that MRSA can be retrieved from animals, retail meat, poultry, fowl, and their products (O’Brien et al., 2012; Peter et al., 2022; Tyasningsih et al., 2022). Researchers have discovered that a number of genomic elements encode virulence and resistance genes carried by MRSA. The MRSA mecA gene, which contains insertion sites for genetic elements that promote the enhanced acquisition of resistance determinants to other antimicrobials, encodes PBP2a, which has decreased susceptibility to β-lactam antibiotics (Ito et al., 2012). Staphylococcus aureus strains that carry the mecA gene become resistant to methicillin, which is penicillinase. Staphylococcal cassette chromosome mec (SCCmec) contains this gene, which confers resistance to many antibiotics such as penicillin and beta-lactam. The mecA gene-related multidrug-resistant (MDR) S. aureus strains were found in ready-to-eat meat products, chicken giblets, and retail meat products (Darwish et al., 2018; Morshdy et al., 2018). MRSA from poultry chicken meat has been found to contain multiple toxin gene groups, including enterotoxins (sea, seb, sec, sed, see, seg, seh, and sei), exfoliative toxins (eta and atb), leukocidins (lukE, lukD, and lukM), Panton-Valentine leukocidin (lukS and lukF), and hemolysins (hla, hlb, and hld) (Abdalrahman et al., 2015). MRSA (nuc and mecA positive) has also been recovered from chicken, pork, and turkey (Fox et al., 2016). There are limited studies about LA-MRSA strains that are capable of causing zoonotic infections, and other S. aureus infections in Nigeria, especially at Abakaliki in Ebonyi State. Thus, there is a need for this study, which aimed at the prevalence and molecular detection of mecA and lukD genes from LA-MRSA isolated in raw chicken meats sold in Abakaliki. Materials and MethodsStudy design and samplingA cross-sectional study was conducted; layer and broiler chicken fresh raw meat samples were collected from the chicken slaughterhouses located at the live chicken market in Ebonyi State International Market Abakaliki Nigeria. Abakaliki is the capital of Ebonyi State, located in the southeastern part of Nigeria. A total of 150 fresh raw chicken meat samples, which include 75 broilers and 75 layers, were collected randomly from the butchers in the slaughterhouses at the International Market in Abakaliki. Exactly, 10 g each of the fresh raw chicken meat samples were collected using a clean sharp cutting knife and stored in sterile screw-capped containers. The samples were properly labeled, packed in ice packs cool boxes and transported immediately to the Department of Applied Microbiology Laboratory at Ebonyi State University, Abakaliki, Nigeria, for bacteriological analysis. Isolation and identification of S. aureusAfter being weighed, 5 g of the freshly obtained raw chicken meat samples were added to sterile flasks holding 10 ml of enhanced phosphate buffer saline (PBS). A meat grinder was used to thoroughly homogenize the samples in an aseptic setting. The homogenized raw chicken meat samples were diluted, inoculated into peptone water (TITAN Biotech, India) for enrichment, and incubated at 37 °C for 18–24 hours. The samples were subcultured onto a freshly prepared nutrient agar, further cultured on mannitol salt agar (Merck, Darmstadt, Germany), and incubated at 37 °C for 18–24 hours. The well-formed distinct colonies of S. aureus on mannitol salt agar (golden-yellow colonies) were identified phenotypically and biochemically verified using Gram staining, catalase, coagulase test, and characteristic pigment production (Sheet et al., 2021; Tyasningsih et al., 2022). Detection of LA-MRSAOxacillin and cefoxitin antibiotic discs were used to screen the S. aureus isolates from chicken meats for the presence of LA-MRSA. The cefoxitin and oxacillin-impregnated discs were inserted into the inoculated agar plates to identify MRSA. After that, the plates were incubated for 24 hours at 37 °C. The clinical laboratory standard institute was used to assess and interpret the zones of inhibition. The isolates with zone diameters of less or equal to 10 mm for oxacillin and less or equal to 21 mm for cefoxitin were considered resistant (Clinical and Laboratory Standards Institute, 2018; Ukpai et al., 2021). Antibiotic susceptibility testing (AST) of LA-MRSAThe identified isolates of LA-MRSA were subjected to AST by testing six batteries of antibiotic, which were selected from five different antibiotic classes using the Kirby–Bauer disk diffusion technique according to the guideline of Clinical and Laboratory Standards Institute (CLSI). The antimicrobials classes used in this study were beta-lactam [methicillin (oxacillin; OX 5 μg and cefoxitin; FOX 30 μg)], cephalosporins (cefotaxime; CTX 30 μg), macrolides (erythromycin; ERY 30 μg), tetracyclines (tetracyclines; TE 30 μg), and glycopeptides (vancomycin; VAN 30 μg) (Oxoid, UK). To summarize, using a sterile swab stick, each isolate was aseptically injected onto Muller-Hinton Agar (Oxoid, UK) plates after being standardized to 0.5 McFarland equivalents. The inoculated plates were allowed to stand for 15–20 min. Sterile forceps were used to insert the antibiotic discs onto the inoculation plates. Following an 18–24-hour incubation period at 37 °C, the zones of inhibition surrounding each disc were identified, measured to the closest millimeter using a meter rule, documented, and interpreted appropriately (Clinical and Laboratory Standards Institute, 2018). DNA extraction and screening for the presence of lukD and mecA geneIn order to learn more about the LA-MRSA that was verified by oxacillin and cefoxitin, a polymerase chain reaction (PCR) was used to find the lukD and mecA genes (Sheet et al., 2021). The QIAamp DNA Mini Kit (Promega, USA) protocol was followed for the DNA extraction procedure. The primers and PCR technique employed were previously reported by Sheet et al. (2021) and Couto et al. (2016), respectively. Briefly, the genomic DNA of LA-MRSA isolates was extracted from two to three colonies of 24-hour culture. PCR was used to validate the presence of the mecA and lukD genes in the LA-MRSA colonies. Industrial ready-to-used prepared PCR master mix solution (GoTaq Green Master Mix), which contains Taq DNA polymerase, dNTPs, MgCl2, and a reaction buffer at a concentration of 12.5 μl, was used; 10 μl of Sigma water (nuclease-free water), 0.25 μl of forward primer, 0.25 μl of reverse primer, and 2 μl of the genomic DNA were mixed together in a PCR tube. The aliquot of DNA products was amplified using a C1000 Thermo Cycler machine (Bio-Red) for 35 cycles in 25 μl of the PCR reaction mixture. The PCR protocol condition comprised 35 cycles of initial denaturation step of 2 min at 95 °C, followed by denaturation at 94 °C for 30 s, annealing temperature of mecA gene at 54 °C, lukD gene at 55 °C for 30 s, an extension at 72 °C for 30 s, and a final extension at 72 °C for 4 min. Electrophoresis was followed by the visualization of the PCR products. For the electrophoresis analysis, a 1% (w/v) agarose gel was prepared using 1.0 g of agarose (SeaKem, Lonza, USA) and 100 ml of 1X Tris-acetate-ethylenediaminetetraacetate (TAE; pH 8.0) buffer (Bio-Rad, USA). Precisely, one well was filled with 5 μl of Extend Quick-Load DNA Ladder (1 kb; New England, Bio Labs) to gauge band diameters, and another well was filled with 5 μl of negative control (water devoid of nuclease). Consequently, 5 μl of the PCR results from every isolate were meticulously added to the remaining wells. The gel was discolored after 60 minutes with an electric current of 80 V at 400 mA. A gel documentation system (Bio-Rad, USA) was used to visualize and take pictures of the gel. Ethical approvalNot needed for this study. ResultsIsolation of S. aureus bacteriaIn this study, 61 (40.7%) of the 150 chicken meat samples analyzed were positive for S. aureus, of which 39 (52.0%) and 22 (29.3%) S. aureus were isolated from broiler and layer chicken meats, respectively. Out of the 61 (40.7%) samples colonized by S. aureus, 7 (11.5%) were identified to be LA-MRSA positive using the phenotypic method. However, 5 (12.8%) and 2 (9.1%) were recovered as LA-MRSA positive from broiler and layer chicken meats, respectively (Table 1). Sensitivity test resultsThe LA-MRSA isolates in this study were observed to show resistance to beta-lactams (oxacillin and cefoxitin), cephalosporins (cefotaxime), macrolides (erythromycin), tetracyclines (tetracyclines), and glycopeptides (vancomycin). All seven S. aureus isolates were observed to present three major patterns of MDR (Fig. 1). The isolates BM28 and LM17 had a similar pattern of MDR, which is OX-FOX-TE-ERY-CTX with a prevalence of 2 (28.6%) and a resistance index of 0.8. The isolates BM34, BM41, and BM70 presented an OX-FOX-TE-CTX resistance pattern and 3 (42.9%) prevalence with a resistance index of 0.7. In addition, isolates BM12 and LM55 showed the same MDR pattern as OX-FOX-TE-ERY-CTX-VAN and an average prevalence of 2 (28.6%), with a resistance index of 1.0 (Table 2). Detection of the MRSA encoding mecA and lukD geneThe overall prevalence of mecA and lukD genes was discovered in LA-MRSA to be 2 (28.6%) and 3 (42.9%), respectively (Fig. 2). Thus, out of the 5 LA-MRSA isolates recovered from broiler chicken meats studied, 1 (20.0%) and 2 (40.0%) isolates were identified to harbor mecA and lukD genes, respectively. The two LA-MRSA isolates isolated from layer chicken meats were observed to harbor 1 (50.0%) mecA and 1 (50.0%) lukD genes (Table 3). Table 1. Prevalence of S. aureus and LA-MRSA from chicken meats.
DiscussionIsolation of S. aureus bacteriaLA-MRSA is a prominent drug-resistant bacterium that can spread from animals to humans and is responsible for a wide range of diseases around the world. The current study looked at meat samples from broilers and layers and found that one of the main pathogens causing zoonotic infection is S. aureus, which was shown to be highly prevalent. Exactly, 61 (40.7%) out of the 150 chicken meat samples studied were positive for S. aureus, 39 (52.0%) were from broilers, and 22 (29.3%) were from layer chicken meats. The prevalence of 40.7% reported agreed with the work of Waters et al. (2011) where the isolated 41.0% of S. aureus was found in poultry meat samples. According to Bounar-Kechih et al. (2018), laying chickens carried 42.0%, broiler chickens 12.0%, and bovines 55% of S. aureus. Variable numbers and percentages of S. aureus were also identified in these three species of chickens.
Fig. 1. Multidrug resistance LA-MRSA showing resistant to antibiotics. Oxacillin (OX), cefoxitin (FOX), cefotaxime (CTX), erythromycin (ERY), and vancomycin (VAN). The current observation of this study is also similar to several researchers in different parts of the world who reported different prevalences of S. aureus from poultry meats such as Mamza et al. (2010) who reported 52.5%, Bakheet et al. (2018) who reported 62.8%, and Nworie et al. (2016) who reported 76% prevalence of S. aureus strains. Another study on poultry meat revealed that 42 (72.41%) samples were found positive for S. aureus, which is higher than the report of this research (Sunitha et al., 2017). In the food chain, the contamination of meats, such as chicken by S. aureus, is a serious global issue and the major sources of the contaminants are the food handlers such as the butchers, wholesalers, and retailers of the chicken meat who intend to carry S. aureus in their noses or hands (Tshipamba et al., 2018). The length of time that animals are driven to markets in cages or other vehicles contributes to the spread of S. aureus among the animals, as does the food-producing animals themselves, which can carry the organisms on their skin, nose, and intestine (Ou et al., 2017). Staphylococcus aureus is one of the most significant and widespread foodborne pathogens (Abd El-Ghany, 2021). Staphylococcus aureus produces enterotoxins, which are primarily responsible for food poisoning, and it can cause a wide variety of illnesses, such as septicemia and endocarditis. In 2005, it was determined that animals might also present a health danger to humans due to the discovery of MRSA strains known as LA-MRSA, which have a distinct reservoir in agricultural animals (Thwala et al., 2021). This study identified 7 (11.5%) isolates as LA-MRSA positive out of the 61 (40.7%) samples that were positive for S. aureus. However, 5 (12.8%) and 2 (9.1%) were reported as LA-MRSA positive from broiler and layer chicken meats, respectively. LA-MRSA was found in cattle and poultry at prevalence rates of 6.12% and 6.76%, respectively (Vanderhaeghen et al., 2010). According to another study, there was a 6.76% prevalence of LA-MRSA in chicken flesh from African poultry (Ali et al., 2017). Of the 250 pooled pharyngeal swabs of broiler chickens in The Netherlands, 11 (4.4%) included the LA-MRSA strains (Geenen et al., 2013). LA-MRSA was recovered from nine (7.3%) samples comprising four chicken, three pork, and two turkey products obtained from different butchers and supermarkets (Fox et al., 2016). Friese et al. (2013) revealed the presence of LA-MRSA in broiler samples at a rate of 50%–54% and in turkey samples at 62%–77%. Table 2. Multidrug-resistant pattern of LA-MRSA isolated from chicken meats.
Fig. 2. Gel image showing amplification of mecA and lukD genes among the LA-MRSA isolates. Lane M=1 kb Marker, Lane LI17 and BI41=mecA gene, Lane BI12, BI28, and LI55=lukD gene, Lane BI34 and BI70=mecA and lukD genes negative, and −C=negative control. Table 3. Prevalence of mecA and lukD genes in LA-MRSA isolated from chicken meats.
In western Nigeria, MRSA strains were found in broiler chickens with a high incidence rate of 90% (Adeyeye and Adewale, 2013). Comparable studies conducted in Northern Algeria showed that LA-MRSA was present in 23.9% and 6.4% of laying and broiler chicks retrieved from slaughterhouses, respectively (Bounar-Kechih et al., 2018). Karmi (2013) reported a 44.0% prevalence of MRSA in poultry in Egypt; in Nigeria, Kenya, and Cameroon, the prevalence of MRSA range is between 30.0% and less than 10.0% in Tunisia (Bounar-Kechih et al., 2018). This current research indicated that the prevalence of LA-MRSA in chicken meat may be high, and indeed, meats can be contaminated by pathogens. The prevalence of LA-MRSA has been reported in pork meat (Verhegghe et al., 2016). Rather than coming from other sources, animal carcass contamination is the primary cause of LA-MRSA prevalence. Therefore, the frequency of LA-MRSA in the animal itself is closely correlated with its prevalence; however, this does not rule out cross-contamination during processing and slaughter, which may result from the butchers’ hands and utensils (Thwala et al., 2021). The entry points are infected transport vehicles, direct contact with human colonists, and the transfer of MRSA-colonized animals from one farm to another (Grøntvedt et al., 2016; Crespo-Piazuelo and Lawlor, 2021). Sensitivity test resultsThe LA-MRSA presented different patterns of MDR, which include OX-FOX-TE-ERY-CTX, OX-FOX-TE-CTX, and OX-FOX-TE-ERY-CTX-VAN with an average index of 0.8, and is similar with the 0.6 MAR index reported in broiler chickens with resistance patterns as OXA-PEN-FOX-ERY and OXA-PEN-FOX-TCY-ENR-ERY (Bounar-Kechih et al., 2018). Research done on LA-MRSA in Korea documented resistance to ampicillin, cefoxitin, erythromycin, and tetracyclines, the patterns of MDR, including AMP-CLI-ERY-FOX-TE (Seung et al., 2020) and by the observation of this study. Nworie et al. (2016), in their study on MDR S. aureus from layers and broilers chicken, reported MRSA to show resistance to cefotaxime, cefoxitin, erythromycin, tetracyclines, chloramphenicol, doxycycline, gentamycin, and levofloxacin, with a resistance pattern as FOX-TE-ERY-CTX-CHL-DOX-GEN and an average index of 3.0. Another study on MRSA in village chickens from poultry markets demonstrated resistance patterns as ET-SXT-VAN-FOX-NA-ERY and VAN-FOX-NA-ERY (Kwoji et al., 2019). Gaddafi et al. (2022) reported MRSA to show resistance for erythromycin, oxytetracycline, neomycin, penicillin, sulfonamide, and gentamicin, with resistance patterns as ERY-OXY-NEO-PEN-SUL-GEN and OXY-NEO-PEN-SUL, and Fox et al. (2016) documented PEN-OXA-TET. The MDR found in LA-MRSA is linked to mobile genetic elements that carry the resistance marker. Due to antibiotic selection pressure in humans or livestock, these MDR determinants can spread throughout a community, region, or subregion. Detection of the MRSA encoding mecA and lukD geneThe mecA gene was reported in MRSA, 40.0% from broiler chicken and 60.0% from the local chicken in Nigeria (Musawa et al., 2020). The presence of mecA gene has been reported from LA-MRSA to have a wide geographical distribution with a large diversity of hosts such as domestics/wildlife, companion animals, poultry birds, other food chain, and animal production wastewater samples, which is a threat to public health (Aires-de-Sousa, 2017; Decline et al., 2020; Yunita et al., 2020). According to earlier studies, S. aureus developed resistance to beta-lactam and methicillin drugs by acquiring the mec gene, which is found in the SCCmec element (Li et al., 2017; Thwala et al., 2021). Multiple mutations can occur in the mecA gene promoter, which could be a factor in the decline in oxacillin activity (Chen et al., 2014; Khairullah et al., 2020). The mecA gene was detected in MDR-MRSAstrains isolated from milk (Ramandinianto et al., 2020; Khairullah et al., 2022), chicken meat and giblets (Morshdy et al., 2018), ready-to-eat meat (Abd El-Ghany, 2021), and fresh retail meat (Darwish et al., 2018) and is by the observation of this study. The virulence toxin genes of the leukocidins (lukE, lukD, and lukM) and Panton-Valentine leukocidins (lukS and lukF) were found in MRSA from retail chicken and turkey meat in Oklahoma, and their results are consistent with the current data (Abdalrahman et al., 2015). ConclusionThis research reported the prevalence of LA-MSRA at a reasonable height in raw broiler and layer chicken meat consumed by the general public in Abakaliki and this could lead to public health problems if not monitored. It further detected mecA and lukD genes in LA-MRSA from chicken, which may bring about a serious public health risk to the general population who depends on chicken meats as a source of protein and poultry farm workers or slaughters due to possible animal-to-human transmission. Therefore, there is a need for veterinarians and public health officers to introduce policies and preventive measures to control the rate of LA-MRSA spread in poultry farms. AcknowledgmentsThe authors thank Universitas Airlangga. Conflict of interestThe authors declare that there is no conflict of interest. FundingThe authors would like to acknowledge Ebonyi State University, Abakaliki Nigeria, and Lembaga Penelitian dan Pengabdian Masyarakat, Universitas Airlangga, Indonesia, for their support. This study was partly supported by the International Research Consortium, Lembaga Penelitian dan Pengabdian Masyarakat, Universitas Airlangga, Surabaya, Indonesia, Year 2024 with grant number: 171/UN3.LPPM/PT.01.03/2024. Authors’ contributionsENU and AIU: conceived, designed, and coordinated the study. BNA and IBM: designed data collection tools, supervised the field sample and data collection, and laboratory work as well as data entry. MHE and WT: validation, supervision, and formal analysis. ACN: contributed reagents, materials, and analysis tools. SMY, RR, and ARK: carried out the statistical analysis and interpretation and participated in the preparation of the manuscript. All authors have read, reviewed, and approved the final manuscript. Data availabilityAll data are available in the manuscript. ReferencesAbd El-Ghany, W.A. 2021. Staphylococcus aureus in poultry, with special emphasis on methicillin-resistant strain infection: a comprehensive review from one health perspective. Int. J. One Health 7(2), 257–267. Abdalrahman, L.S., Stanley, A., Wells, H. and Fakhr, M.K. 2015. Isolation, virulence, and antimicrobial resistance of methicillin-resistant Staphylococcus aureus (MRSA) and methicillin-sensitive Staphylococcus aureus (MSSA) strains from Oklahoma retail poultry meats. Int. J. Environ. Res. Public Health. 12(6), 6148–6161. Abolghait, S.K., Fathi, A.G., Youssef, F.M. and Algammal, A.M. 2020. Methicillin-resistant Staphylococcus aureus (MRSA) isolated from chicken meat and giblets often produces staphylococcal enterotoxin B (SEB) in non-refrigerated raw chicken livers. Int. J. Food Microbiol. 328(1), 108669. Adeyeye, J. and Adewale, A. 2013. Incidence of methicillin-resistant Staphylococcus aureus (MRSA) in a small poultry in South West, Nigeria. IOSR J. Agric. Vet. Sci. 5(3), 53–55. Aires-de-Sousa, M. 2017. Methicillin-resistant Staphylococcus aureus among animals: current overview. Clin. Microbiol. Infect. 23(6), 373–380. Ali, Y., Islam, M.A., Muzahid, N.H., Sikder, M.O.F., Hossain, M.A. and Marzan, L.W. 2017. Characterization, prevalence and antibiogram study of Staphylococcus aureus in poultry. Asian Pac. J. Trop. Biomed. 7(3), 253–256. Bakheet, A.A., Amen, O., Habaty, S.H. and Darwish, S.F. 2018. Prevalence of Staphylococcus aureus in broiler chickens with special reference to beta-lactam resistance genes in the isolated strains. Alex. J. Vet. Sci. 57(2), 25–33. Benrabia, I., Hamdi, T.M., Shehata, A.A., Neubauer, H. and Wareth, G. 2020. Methicillin-resistant Staphylococcus aureus (MRSA) in poultry species in Algeria: Long-term study on prevalence and antimicrobial resistance. Vet. Sci. 7(2), 54. Bounar-Kechih, S., Hamdi, M.T., Aggad, H., Meguenni, N. and Cantekin, Z. 2018. Carriage Livestock Acquired Methicillin-Resistant Staphylococcus aureus in Poultry and Cattle in Northern Algeria. Vet. Med. Int. 2018(1), 4636121. Chen, F.J., Wang, C.H., Chen, C.Y., Hsu, Y.C. and Wang, K.T. 2014. Role of the mecA gene in oxacillin resistance in a Staphylococcus aureus clinical strain with a pvl-positive ST59 genetic background. Antimicrob. Agents Chemother. 58(2), 1047–1054. Clinical and Laboratory Standards Institute. 2018. M100 performance standards for antimicrobial susceptibility testing. 28th ed. Clinical and Laboratory Standards Institute. www.clsi.org. Published in Wayne City, PA. Couto, N., Belas, A., Oliveira, M., Almeida, P., Clemente, C. and Pomba, C. 2016. Comparative RNA-seq-based transcriptome analysis of the virulence characteristics of methicillin-resistant and-susceptible Staphylococcus pseudintermedius strains isolated from small animals. Antimicrob. Agents Chemother. 60(2), 962–967. Crespo-Piazuelo, D. and Lawlor, P.G. 2021. Livestock-associated methicillin-resistant Staphylococcus aureus (LA-MRSA) prevalence in humans in close contact with animals and measures to reduce on-farm colonization. Irish Vet. J. 74(1), 21. Darwish, W.S., Atia, A.S., Reda, L.M., Elhelaly, A.E., Thompson, L.A. and Eldin, W.F.S. 2018. Chicken giblets and wastewater samples as possible sources of methicillin-resistant Staphylococcus aureus: prevalence, enterotoxin production, and antibiotic susceptibility. J. Food Saf. 38(10), e12478. Decline, V., Effendi, M.H., Rahmaniar, R.P., Yanestria, S.M. and Harijani, N. 2020. Profile of antibiotic-resistant and presence of methicillin-resistant Staphylococcus aureus from nasal swab of dogs from several animal clinics in Surabaya, Indonesia. Int. J. One Health 6(1), 90–94. Effendi, M.H., Oktavianto, A. and Hastutiek, P. 2018. Tetracycline resistance gene in Streptococcus agalactiae isolated from bovine subclinical mastitis in Surabaya, Indonesia. Philipp. J. Vet. Med. 55(SI), 115–120. Fox, A., Pichon, B., Wilkinson, H., Doumith, M., McLauchlin, J. and Kearns, A.M. 2016. Detection and molecular characterization of livestock-associated MRSA in raw meat on retail sale in North West England. Lett. Appl. Microbiol. 64(3), 239–245. Friese, A., Schulz, J., Zimmermann, K., Tenhagen, B.A., Fetsch, A., Hartung, J. and Röslera, U. 2013. Occurrence of livestock-associated methicillin-resistant Staphylococcus aureus in Turkey and broiler barns and contamination of air and soil surfaces in their vicinity. Appl. Environ. Microbiol. 79(8), 2759–2766. Gaddafi, M.S., Yakubu, Y., Bello, M.B., Bitrus, A.A., Musawa, A.I., Garba, B., Lawal, H., Aliyu, M.A., Barka, S.A. and Emeka, A.J. 2022. Occurrence and antibiotic resistance profilrs of MRSA in layer chicken in Kebbi Nigeria. Folia Vet. 66(2), 37–45. Geenen, P.L., Graat, E.A.M., Haenen, A., Hengeveld, P.D., Van Hoek, A.H.A.M., Huijsdens, X.W., Kappert, C.C., Lammers, G.A.C., Van Duijkeren, E. and Van De Giessen, A.W. 2013. Prevalence of livestock-associated MRSA on Dutch broiler farms and in people living and/or working on these farms. Epidemiol. Infect. 141(5), 1099–1108. Grøntvedt, C.A., Elstrøm, P., Stegger, M., Skov, R.L., Andersen, P.S., Larssen, K.W., Urdahl, A.M., Angen, Ø., Larsen, J., Åmdal, S., Løtvedt, S.M., Sunde, M. and Bjørnholt, J.V. 2016. Methicillin-resistant Staphylococcus aureus CC398 in humans and pigs in Norway: a “one health” perspective on introduction and transmission. Clin. Infect. Dis. 63(11), 1431–1438. Ito, T., Hiramatsu, K., Tomasz, A., de Lencastre, H., Perreten, V., Holden, M.T., Coleman, D.C., Goering, R., Giffard, P.M., Skov, R.L., Zhang, K., Westh, H., O’Brien, F., Tenover, F.C., Oliveira DC, Boyle-Vavra S, Laurent F, Kearns AM, Kreiswirth B, Ko KS, Grundmann H, Sollid, J.E., John, J.F., Daum, R., Soderquist, B. and Buist, G. 2012. Guidelines for reporting novel mecA gene homologues. Antimicrob. Agents Chemother. 56(10), 4997–4999. Karmi, M. 2013. Prevalence of methicillin-resistant Staphylococcus aureus in poultry meat in Qena, Egypt. Vet. World 6(10), 711–715. Khairullah, A.R., Ramandinianto, S.C. and Effendi, M.H. 2020. A review of livestock-associated methicillin-resistant Staphylococcus aureus (LA-MRSA) on bovine mastitis. Syst. Rev. Pharm. 11(7), 172–183. Khairullah, A.R., Sudjarwo, S.A., Effendi, M.H., Ramandinianto, S.C., Gelolodo, M.A., Widodo, A., Riwu, K.H.P. and Kurniawati, D.A. 2023. Pet animals as reservoirs for spreading methicillin-resistant Staphylococcus aureus to human health. J. Adv. Vet. Anim. Res. 10(1), 1–13. Kinross, P., Petersen, A., Skov, R., Van Hauwermeiren, E., Pantosti, A., Laurent, F., Voss, A., Kluytmans, J., Struelens, M.J., Heuer, O. and Monnet, D.L. 2017. Livestock-associated methicillin-resistant Staphylococcus aureus (MRSA) among human MRSA isolates, European Union/European Economic Area countries, 2013. Euro Surveill. 22(44), 16-00696. Kwoji, I.D., Jauro, S., Musa, J.A., Lekko, Y.M., Salihu, S.I. and Danchuwa, H.A. 2019. Phenotypic detection of methicillin-resistant Staphylococcus aureus in village chickens from poultry markets in Maiduguri, Nigeria. J. Adv. Vet. Anim. Res. 6(2), 163–167. Li, J., Jiang, N., Ke, Y., Fessler, A.T., Wang, Y., Schwarz, S. and Wu, C. 2017. Characterization of pig-associated methicillin-resistant Staphylococcus aureus. Vet. Microbiol. 201(1), 183–187. Mamza, S.A., Egwu, G.O. and Mshelia, G.D. 2010. Beta-lactamase-producing Escherichia coli and Staphylococcus aureus isolated from chickens in Nigeria. Vet. Ital. 46(2), 155–165. Morshdy, A.M.A., Darwish, W.S., El-Dien, W.M.S. and Khalifa, S.M. 2018. Prevalence of multidrug-resistant Staphylococcus aureus and Salmonella Enteritidis in meat products retailed in Zagazig city, Egypt. Slov. Vet. Res. 55(Suppl 20), 295–300. Musawa, I.A., Yakubu, Y., Garba, B., Ballah, F.M., Jibril, H.A., Bello, A.S., Sani, M.G. and Farida, A. 2020. Dressed chicken as potential vehicle for spread of methicillin-resistant Staphylococcus aureus in Sokoto, Nigeria. Future Sci. OA 6(10), FSO619. Nworie, A., Elom, M.O., Gideon, I.A., Azi, S.O., Okekpa, S.I., Ukwah, B.N., Usanga, V.U., Okon, U.N., Chinwe, E., Olayinka, B.O., Onaolapo, J.A. and Ehinmidu, J.O. 2016. Multi-drug resistant Staphylococcus aureus from poultry farms in Ebonyi state, Nigeria. Int. J. Micro Biol. Genet. Monocul. Biol. Res. 2(3), 1–11. O’Brien, A.M., Hanson, B.M., Farina, S.A., Wu, J.Y., Simmering, J.E., Wardyn, S.E., Forshey, B.M. and Kulick, M.E. 2012. MRSA in conventional and alternative retail pork products. PLoS One 7(1), e30092. Ou, Q., Peng, Y., Lin, D., Bai, C., Zhang, T., Lin, J., Ye, X. and Yao, Z. 2017. A Meta-Analysis of the global prevalence rates of Staphylococcus aureus and methicillin-resistant S. aureus contamination of different raw meat products. J. Food Protect. 80(5), 763–774. Peter, I.U., Ngwu, J.N., Edemekong, C., Ugwueke, I.V. and Uzoeto, H. 2022. First report prevalence of livestock acquired methicillin resistant Staphylococcus aureus (LA-MRSA) strain in South Eastern, Nigeria. IOSR J. Nurs. Health Sci. 11(1), 50–56. Ramandinianto, S.C., Khairullah, A.R. and Effendi, M.H. 2020. mecA gene and methicillin resistant Staphylococcus aureus (MRSA) isolated from dairy farms in East Java, Indonesia. Biodiversitas 21(8), 3562–3568. Seung, H.B., Hong, S.E., Haeng, H.L., Yong, L.G., Kun, T.P. and Soo-Jin, Y. 2020. Livestock-associated methicillin-resistant Staphylococcus aureus in Korea: antimicrobial resistance and molecular characteristics of LA-MRSA strains isolated from pigs, pig farmers, and farm environment. J. Vet. Sci. 21(1), e2. Sheet, O.H., Hussien, S.A. and Alchalaby, A.Y. 2021. Detection of methicillin-resistant Staphylococcus aureus from broiler carcasses in Mosul City. Iraqi J. Vet. Sci. 35(3), 489–493. Suleyman, G., Alangaden, G. and Bardossy, A.C. 2018. The role of environmental contamination in the transmission of nosocomial pathogens and healthcare-associated infections. Curr. Infect. Dis. Rep. 20(6), 12. Sunitha, S., Vinod, R.R., Sunil, B. and Prejit, P. 2017. Characterisation and antibiotic sensitivity of Staphylococcus aureus and methicillin resistant Staphylococcus aureus isolated from poultry meat. Int. J. Livest. Res. 7(10), 46–52. Thwala, T., Madoroba, E., Basson, A. and Butaye, P. 2021. Prevalence and characteristics of Staphylococcus aureus associated with meat and meat products in african countries: a review. Antibiotics 10(9), 1108. Touimi, G.B., Bennani, L., Berrada, S., Moussa, B. and Bennani, B. 2020. Prevalence and antibiotic resistance profiles of Staphylococcus sp. isolated from food, food contact surfaces and food handlers in a Moroccan hospital kitchen. Lett. Appl. Microbiol. 70(4), 241–251. Tshipamba, M.E., Lubanza, N., Adetunji, M.C. and Mwanza, M. 2018. Molecular characterization and antibiotic resistance of foodborne pathogens in street-vended ready-to-eat meat sold in South Africa. J. Food Protect. 81(12), 1963–1972. Tyasningsih, W., Effendi, M.H., Budiarto, B. and Syahputra, I.R. 2019. Antibiotic resistance to Staphylococcus aureus and methicillin resistant Staphylococcus aureus (MRSA) isolated from dairy farms in Surabaya, Indonesia. Indian Vet. J. 96(11), 27–31. Tyasningsih, W., Ramandinianto, S.C., Ansharieta, R., Witaningrum, A.M., Permatasari, D.A., Wardhana, D.K., Effendi, M.H. and Ugbo, E.N. 2022. Prevalence and antibiotic resistance of Staphylococcus aureus and Escherichia coli isolated from raw milk in East Java, Indonesia. Vet. World 15(8), 2021–2028. Ukpai, E.G., Chukwura, E.I., Moses, I.B., Ugbo, E.N., Agumah, N.B., Okata-Nwali, O.D., Anakwenze, V.N., Nnabugwu, C.C., Onodagu, B.O., Ogu, G.I., Igborgbor, J.C. and Okoye, C.S. 2021. Prevalence and antibiogram of healthcare-associated methicillin-resistant Staphylococcus aureus (HA-MRSA) in Ebonyi State, Nigeria. Int. J. Pharm. Sci. Rev. Res. 69(1), 104–111. Vanderhaeghen, W., Hermans, K., Haesebrouck, F. and Butaye, P. 2010. Methicillin-resistant Staphylococcus aureus (MRSA) in food production animals. Epidemiol. Infect. 138(5), 606–625. Verhegghe, M., Crombe, F., Luyckx, K., Haesebrouck, F., Butaye, P., Herman, L., Heyndrickx, M. and Rasschaert, G. 2016. Prevalence and genetic diversity of livestock-associated methicillin-resistant Staphylococcus aureus on Belgian pork. J. Food Protect. 79(1), 82–89. Waters, A.E., Contente-Cuomo, T., Buchhagen, J., Liu, C.M., Watson, L., Pearce, K., Foster, J.T., Bowers, J., Driebe, E.M., Engelthaler, D.M. and Keim, P.S. 2011. Multidrug-resistant Staphylococcus aureus in US meat and poultry. Clin. Infect. Dis. 52(10), 1227–1230. Wu, S., Huang, J. and Zhang, F. 2019. Prevalence and characterization of food-related methicillin-resistant Staphylococcus aureus (MRSA) in China. Front. Microbiol. 10(1), 304. Yunita, M.N., Effendi, M.H., Rahmaniar, R.P., Arifah, S. and Yanestria, S.M. 2020. Identification of spa gene for strain typing of methicillin resistant Staphylococcus aureus (MRSA) isolated from nasal swab of dogs. Biochem. Cell. Arch. 20(1), 2999–3004. | ||
| How to Cite this Article |
| Pubmed Style Ugbo EN, Ugbo AI, Effendi MH, Tyasningsih W, Agumah BN, Nwachi AC, Khairullah AR, Moses IB, Raissa R, Yanestria SM. Prevalence and molecular detection of mecA and lukD genes from livestock-associated methicillin-resistant Staphylococcus aureus isolated in raw chicken meats sold in Abakaliki, Nigeria. Open Vet. J.. 2024; 14(12): 3327-3335. doi:10.5455/OVJ.2024.v14.i12.17 Web Style Ugbo EN, Ugbo AI, Effendi MH, Tyasningsih W, Agumah BN, Nwachi AC, Khairullah AR, Moses IB, Raissa R, Yanestria SM. Prevalence and molecular detection of mecA and lukD genes from livestock-associated methicillin-resistant Staphylococcus aureus isolated in raw chicken meats sold in Abakaliki, Nigeria. https://www.openveterinaryjournal.com/?mno=217081 [Access: June 26, 2026]. doi:10.5455/OVJ.2024.v14.i12.17 AMA (American Medical Association) Style Ugbo EN, Ugbo AI, Effendi MH, Tyasningsih W, Agumah BN, Nwachi AC, Khairullah AR, Moses IB, Raissa R, Yanestria SM. Prevalence and molecular detection of mecA and lukD genes from livestock-associated methicillin-resistant Staphylococcus aureus isolated in raw chicken meats sold in Abakaliki, Nigeria. Open Vet. J.. 2024; 14(12): 3327-3335. doi:10.5455/OVJ.2024.v14.i12.17 Vancouver/ICMJE Style Ugbo EN, Ugbo AI, Effendi MH, Tyasningsih W, Agumah BN, Nwachi AC, Khairullah AR, Moses IB, Raissa R, Yanestria SM. Prevalence and molecular detection of mecA and lukD genes from livestock-associated methicillin-resistant Staphylococcus aureus isolated in raw chicken meats sold in Abakaliki, Nigeria. Open Vet. J.. (2024), [cited June 26, 2026]; 14(12): 3327-3335. doi:10.5455/OVJ.2024.v14.i12.17 Harvard Style Ugbo, E. N., Ugbo, . A. I., Effendi, . M. H., Tyasningsih, . W., Agumah, . B. N., Nwachi, . A. C., Khairullah, . A. R., Moses, . I. B., Raissa, . R. & Yanestria, . S. M. (2024) Prevalence and molecular detection of mecA and lukD genes from livestock-associated methicillin-resistant Staphylococcus aureus isolated in raw chicken meats sold in Abakaliki, Nigeria. Open Vet. J., 14 (12), 3327-3335. doi:10.5455/OVJ.2024.v14.i12.17 Turabian Style Ugbo, Emmanuel Nnabuike, Agatha Ifunanya Ugbo, Mustofa Helmi Effendi, Wiwiek Tyasningsih, Bernard Nnabuife Agumah, Anthonia Chinyere Nwachi, Aswin Rafif Khairullah, Ikechukwu Benjamin Moses, Ricadonna Raissa, and Sheila Marty Yanestria. 2024. Prevalence and molecular detection of mecA and lukD genes from livestock-associated methicillin-resistant Staphylococcus aureus isolated in raw chicken meats sold in Abakaliki, Nigeria. Open Veterinary Journal, 14 (12), 3327-3335. doi:10.5455/OVJ.2024.v14.i12.17 Chicago Style Ugbo, Emmanuel Nnabuike, Agatha Ifunanya Ugbo, Mustofa Helmi Effendi, Wiwiek Tyasningsih, Bernard Nnabuife Agumah, Anthonia Chinyere Nwachi, Aswin Rafif Khairullah, Ikechukwu Benjamin Moses, Ricadonna Raissa, and Sheila Marty Yanestria. "Prevalence and molecular detection of mecA and lukD genes from livestock-associated methicillin-resistant Staphylococcus aureus isolated in raw chicken meats sold in Abakaliki, Nigeria." Open Veterinary Journal 14 (2024), 3327-3335. doi:10.5455/OVJ.2024.v14.i12.17 MLA (The Modern Language Association) Style Ugbo, Emmanuel Nnabuike, Agatha Ifunanya Ugbo, Mustofa Helmi Effendi, Wiwiek Tyasningsih, Bernard Nnabuife Agumah, Anthonia Chinyere Nwachi, Aswin Rafif Khairullah, Ikechukwu Benjamin Moses, Ricadonna Raissa, and Sheila Marty Yanestria. "Prevalence and molecular detection of mecA and lukD genes from livestock-associated methicillin-resistant Staphylococcus aureus isolated in raw chicken meats sold in Abakaliki, Nigeria." Open Veterinary Journal 14.12 (2024), 3327-3335. Print. doi:10.5455/OVJ.2024.v14.i12.17 APA (American Psychological Association) Style Ugbo, E. N., Ugbo, . A. I., Effendi, . M. H., Tyasningsih, . W., Agumah, . B. N., Nwachi, . A. C., Khairullah, . A. R., Moses, . I. B., Raissa, . R. & Yanestria, . S. M. (2024) Prevalence and molecular detection of mecA and lukD genes from livestock-associated methicillin-resistant Staphylococcus aureus isolated in raw chicken meats sold in Abakaliki, Nigeria. Open Veterinary Journal, 14 (12), 3327-3335. doi:10.5455/OVJ.2024.v14.i12.17 |